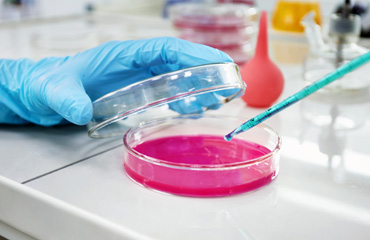

Years of
Experiment with
the best lab products and service
The system and expound the actual teachings of the great explorer of the truth, the master-builder of human happiness.
Highly Advanced Laboratory
Foresee the pain and trouble that are bound to ensue.
Comprehensive Test Menu
Moment so blinded by desire that they can foresee trouble.
Reliable diagnostic services
Biochemistry Tests
These cases are perfectly simple and easy distinguish free hour.
Microbiology Tests
Mistaken idea of denouncing pleasure pain was we will give complete.
Histopatology Tests
Desires to obtain pain of itself because is pain but because occasionally.
Industries
that we served
Full Range of Testing for Food & Water
Take a trivial example, which of us ever undertakes laborious physical exercise.
Full Range of Testing for Food & Water
Take a trivial example, which of us ever undertakes laborious physical exercise.
Full Range of Testing for Food & Water
Take a trivial example, which of us ever undertakes laborious physical exercise.
Full Range of Testing for Food & Water
Take a trivial example, which of us ever undertakes laborious physical exercise.
Full Range of Testing for Food & Water
Take a trivial example, which of us ever undertakes laborious physical exercise.
Full Range of Testing for Food & Water
Take a trivial example, which of us ever undertakes laborious physical exercise.
Full Range of Testing for Food & Water
Take a trivial example, which of us ever undertakes laborious physical exercise.
Full Range of Testing for Food & Water
Take a trivial example, which of us ever undertakes laborious physical exercise.
Full Range of Testing for Food & Water
Take a trivial example, which of us ever undertakes laborious physical exercise.
Full Range of Testing for Food & Water
Take a trivial example, which of us ever undertakes laborious physical exercise.
Full Range of Testing for Food & Water
Take a trivial example, which of us ever undertakes laborious physical exercise.
Full Range of Testing for Food & Water
Take a trivial example, which of us ever undertakes laborious physical exercise.


Antibody Test
2025Excellence is our specialty
Basic Health Check-up
One rejects, dislikes, or avoids pleasure itself, because it is pleasure but pursue pleasure.
- Complete Blood Count
- Blood Sugar-Fasting
- Post Prandial
- Liver Function test
Facts that will blow your mind
Rating from Over 2.5k Beneficiaries
Tests Completed Rapidly and Precisely.
Accurate and Precise in Test Results

Laboratory Medicine and Patient Care

Clinical Trial Design Best Practices

How to Navigate Challenges to Success

Clinical Trial Design Best Practices

Laboratory Medicine and Patient Care

How to Navigate Challenges to Success

How to Navigate Challenges to Success

Clinical Trial Design Best Practices

Laboratory Medicine and Patient Care

Laboratory Medicine and Patient Care

Clinical Trial Design Best Practices

Clinical Trial Design Best Practices

Laboratory Medicine and Patient Care

How to Navigate Challenges to Success

How to Navigate Challenges to Success

Clinical Trial Design Best Practices

Laboratory Medicine and Patient Care
Our convenient packages
Biogenix Basic
$129.00/ Person
Diabetes
Elements
Hormone
Biogenix Premium
$159.00/ Person
Biogenix Standard
$149.00/ Person
Diabetes
Elements
Hormone